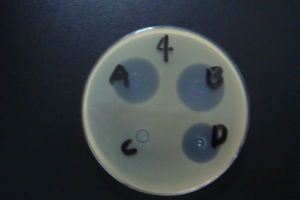
β-內醯胺酶檢測

簡介
 細菌耐藥性的機制之一—產生β-內醯胺酶
細菌耐藥性的機制之一—產生β-內醯胺酶β-內醯胺酶是由多種酶組成的酶家族,通過水解或非水解方式破壞進入菌體內的β-內醯胺環,導致β-內醯胺類抗生素失活,這些酶的基因存在於細菌的染色體或質粒中。它的種類和數量現已超過了400種。其檢測方法包括常規方法和分子生物學方法。前者包括微生物法、碘量法、紙片酸度定量法、產色頭孢菌素法;後者包括轉移性分析、基因分析、酶蛋白性質分析。
β-內醯胺酶在食品中作為解抗劑,但是“生鮮牛乳抗生素分解劑”的主要成分β-內醯胺酶是中國不允許使用的食品添加劑。
合成、定位及傳播方式
自然條件下,β-內醯胺酶既可以在細菌內組成型表達,如銅綠假單胞菌;又可以由質粒介導的誘導表達,如嗜水氣單胞菌及金黃色葡萄球菌。而質粒介導的方式是細菌耐藥性傳播的一個主要機制,在革蘭氏陰性菌中利用接合的方式進行傳播,而在革蘭氏陽性菌中利用轉導的方式獲得耐藥性狀。細菌的這種耐藥性狀的可轉移性正是細菌耐藥性爆發的原因。在革蘭氏陰性菌中,β內醯胺酶像胞外酶一樣被分泌到膜外的環境,而在革蘭氏陽性菌中,β內醯胺酶在它與受體結合以攻擊抗生素的之前則停留在周質腔中 。分類
β-內醯胺酶檢測
β-內醯胺酶檢測1.β-內醯胺酶的功能學分類
已有幾種標準來用於β-內醯胺酶的分類,包括抗生素的抑菌的作用範圍,β-內醯胺酶的耐藥範圍,β-內醯胺酶的等電點、最大水解速度、結合常數、等電聚焦、蛋白分子量等方法。最新的分類方法是Bush於1995年提出,他將β內醯胺酶分為四個大類(1-4)及六個亞類(a-f)。
第1類 為耐頭孢菌素的β內醯胺酶,但不被克拉維酸所抑制,分子生物學分類屬於C類。
第2類 為耐青黴素酶、耐頭孢菌素酶,可以被克拉維酸所抑制,分子生物學分類屬於A和D類,是由最初的TEM和SHV基因表達的結果。但由於表達的β-內醯胺酶的TEM和SHV基因數量越來越多,它們首先被分為兩個亞類2a和2b。2a亞類只包括耐青黴素酶,而2b亞類範圍較廣,它可以使青黴素、頭孢菌素以同樣速度失活。進一步的分類都是在2b基礎上劃分的:亞類2be,字母e代表廣譜酶活性,即ESBLs,可以使第三代頭孢菌素(頭孢他啶、頭孢噻肟、頭孢泊肟)失活,還可以使單內醯環類抗生素(氨曲南)失活;亞類2br,字母r表示減少與克拉維酸及舒巴坦的結合,所以也被稱為TEM基因表達的有抗性的抑制劑,可是它們依然對他佐巴坦敏感。隨後又分出4個亞類,亞類2c是對羧苄青黴素效果比對青黴素要好,而且對氯唑西林有一定的作用。亞類2d的酶對氯唑西林耐藥效果比對青黴素要好,對羧苄青黴素有一定的作用;這些酶很少被克拉維酸所抑制,並且這些酶中的一部分成為ESBLs。亞類2e的這些酶是耐頭孢菌素酶,但同樣可以水解單內醯環類抗生素,也可以被克拉維酸所抑制。亞類2f被加上是因為它們是依賴絲氨酸發揮作用的耐碳青酶烯酶,與第3類中的依賴鋅離子發揮作用的耐碳青酶烯酶形成對比。
第3類是依賴鋅離子或金屬離子的β-內醯胺酶,分子生物學分類屬於B類。它們是唯一的在鋅離子或金屬離子輔助下發揮作用的酶。它們可以水解青黴素、頭孢菌素、碳青酶烯抗生素。這樣,碳青酶烯抗生素既可以被亞類2f酶(絲氨酸作用機制)抑制,又可以第3類酶(鋅離子作用機制)所抑制。
第4類 是不能被克拉維酸所抑制的耐青黴素酶,但目前在分子生物學上沒有分類。
2.β-內醯胺酶的分子生物學分類
β-內醯胺酶的分子生物學分類方法是基於核酸及胺基酸的序列的差異。迄今為止(2013年),人們已經確認了四種類型的β內醯胺酶(A、B、C、D),其中A類、C類和D類β-內醯胺酶是依賴絲氨酸發揮作用,而B類β內醯胺酶是依賴鋅離子或金屬離子輔助下發揮作用的酶。A類酶包括多種質粒編碼的青黴素酶,活性部位為絲氨酸殘基,分子量為29kDa;
B類酶為金屬酶,由染色體或質粒編碼,酶活性需鋅離子參與,可被乙二胺四乙酸(EDTA)抑制;
C類酶的活性部位為絲氨酸殘基,分子量為39kDa,其產生與誘導劑有關;
D類酶又稱為OXA型(水解苯唑西林)β-內醯胺酶。
作用機制
 β-內醯胺酶
β-內醯胺酶β-內醯胺酶破壞β-內醯胺抗生素的β-內醯胺環有兩種作用機制。
第一,絕大多數常見的β-內醯胺酶有一個依賴絲氨酸發揮作用的機制,並且根據胺基酸序列組成分為三類(A,C和D)。通常它們的活性位點具有一個狹窄的縱形溝狀結構,在溝的底部形成了一個空腔(氧陰離子袋),這種疏鬆的構造容易彎曲,便於結合底物。由於β-內醯胺環上的羰基碳在結合β內醯胺酶活性部位的絲氨酸時發生了不可逆的反應,結果使其成為開環物,進而重建了β-內醯胺酶。這類酶對青黴素、頭孢菌素、單內醯環類抗生素都有活性。
第二,是一類不大多見的β-內醯胺酶,被稱為金屬類β-內醯胺酶,或B類β-內醯胺酶。它們的特點是利用一個2價金屬離子,絕大多數為鋅離子,分別與組氨酸或半胱氨酸結合,或同時與二者結合,並與β-內醯胺類抗生素的羰基碳的醯胺鍵相互作用,使其不能發揮作用。這類酶主要對青黴素、頭孢菌素、碳青酶烯類抗生素髮揮作用,但對單內醯環類抗生素無效。
非法使用
β-內醯胺酶可能添加的食品:乳製品,特別是“無抗奶”。β-內醯胺酶類物質被用作牛奶中抗生素的分解劑。
β-內醯胺類抗生素是在牛乳生產中套用最廣泛的抗生素,用於治療牛乳腺炎和其他細菌感染性疾病。按照國家規定,使用抗生素藥物後一定時間內的乳汁,不得作為供人食用的原料。同時國家在《生鮮牛乳收購標準》中規定,生鮮乳中不得檢出抗生素。然而就中國奶牛飼養環境而言,牛奶的絕對“無抗”較難達到,針對這種情況,市場上出現了“抗生素分解劑”,該分解劑可選擇性分解牛奶中殘留的β-內醯胺抗生素,其成分就是β-內醯胺酶。
β-內醯胺酶,可能添加到乳與乳製品中,起到掩蔽抗生素的作用,但是由於該製劑的安全性風險未知,因此所有乳製品生產企業嚴禁在產品中添加此類物質 。.

